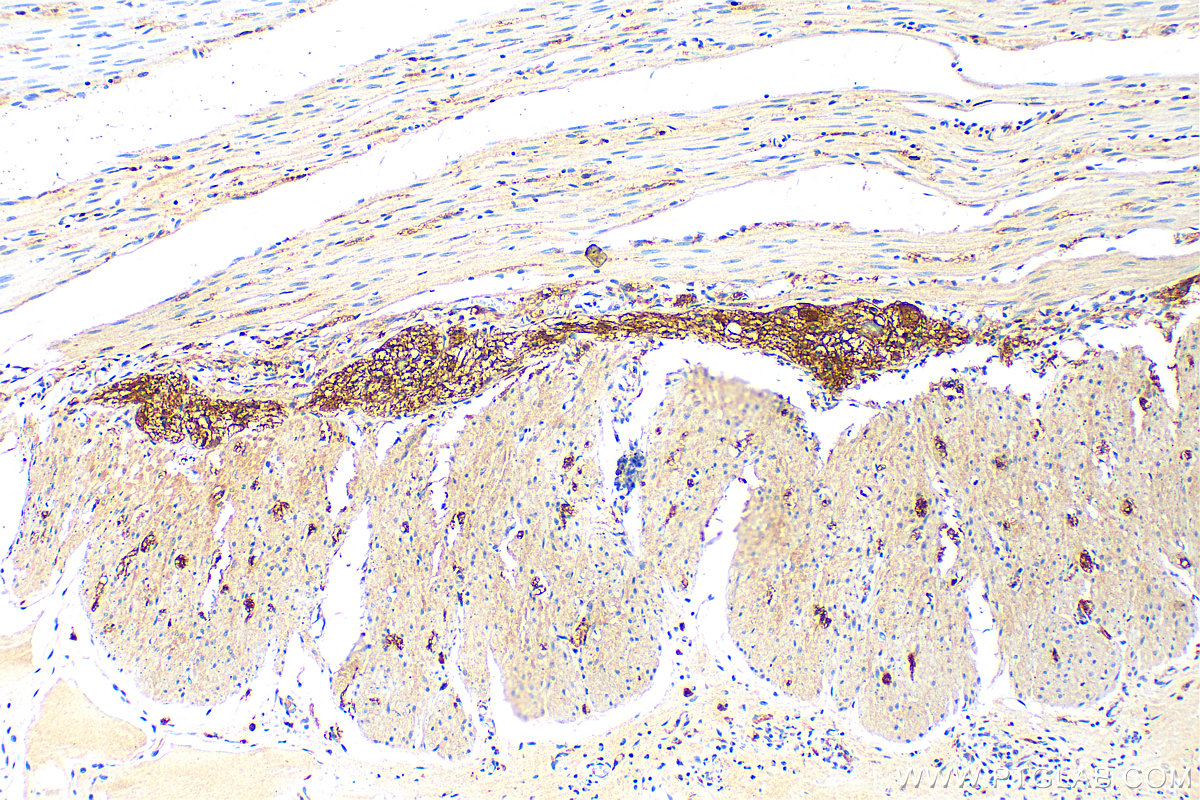

验证数据展示
经过测试的应用
| Positive IHC detected in | human colon tissue, rat small intestine tissue, mouse brain tissue, human small intestine tissue Note: suggested antigen retrieval with TE buffer pH 9.0; (*) Alternatively, antigen retrieval may be performed with citrate buffer pH 6.0 |
| Positive IF-P detected in | mouse colon tissue |
| Positive IF/ICC detected in | HT-29 cells |
推荐稀释比
| 应用 | 推荐稀释比 |
|---|---|
| Immunohistochemistry (IHC) | IHC : 1:400-1:1600 |
| Immunofluorescence (IF)-P | IF-P : 1:50-1:500 |
| Immunofluorescence (IF)/ICC | IF/ICC : 1:200-1:800 |
| It is recommended that this reagent should be titrated in each testing system to obtain optimal results. | |
| Sample-dependent, Check data in validation data gallery. | |
产品信息
16233-1-AP targets VIP in WB, IHC, IF/ICC, IF-P, ELISA applications and shows reactivity with human, mouse, rat samples.
| 经测试应用 | IHC, IF/ICC, IF-P, ELISA Application Description |
| 文献引用应用 | WB, IHC, IF |
| 经测试反应性 | human, mouse, rat |
| 文献引用反应性 | mouse, rat |
| 免疫原 |
CatNo: Ag8933 Product name: Recombinant human VIP protein Source: e coli.-derived, PGEX-4T Tag: GST Domain: 29-169 aa of BC009794 Sequence: YRAPSALRLGDRIPFEGANEPDQVSLKEDIDMLQNALAENDTPYYDVSRNARHADGVFTSDFSKLLGQLSAKKYLESLMGKRVSNISEDPVPVKRHSDAVFTDNYTRLRKQMAVKKYLNSILNGKRSSEGESPDFPEELEK 种属同源性预测 |
| 宿主/亚型 | Rabbit / IgG |
| 抗体类别 | Polyclonal |
| 产品类型 | Antibody |
| 全称 | vasoactive intestinal peptide |
| 别名 | Intestinal peptide PHM-27, Intestinal peptide PHV-42, VIP peptides |
| 计算分子量 | 169 aa, 19 kDa |
| GenBank蛋白编号 | BC009794 |
| 基因名称 | VIP |
| Gene ID (NCBI) | 7432 |
| RRID | AB_2878233 |
| 偶联类型 | Unconjugated |
| 形式 | Liquid |
| 纯化方式 | Antigen affinity purification |
| UNIPROT ID | P01282 |
| 储存缓冲液 | PBS with 0.02% sodium azide and 50% glycerol, pH 7.3. |
| 储存条件 | Store at -20°C. Stable for one year after shipment. Aliquoting is unnecessary for -20oC storage. |
背景介绍
Vasoactive intestinal peptide (VIP), a short peptide containing 28 amino acids belonging to the secretin-glucagon family, is initially isolated from the gastrointestinal tract as a potent vasodilator peptide. VIP was initially identified in normal nervous tissue and neurons and was subsequently recognized as a neurotransmitter widely distributed in various tissues. The wide distribution of VIP determines its involvement in a range of biological activities, such as gut motility, hormonal regulation, circadian rhythms, immune responses, and carcinogenesis. The general physiologic effects of VIP include vasodilation, anti-inflammatory actions, cell proliferation, hormonal secretion, regulation of gastric motility, and smooth muscle relaxation; therefore, VIP has emerged as a promising drug candidate for the treatment of several diseases.
实验方案
| Product Specific Protocols | |
|---|---|
| IF protocol for VIP antibody 16233-1-AP | Download protocol |
| IHC protocol for VIP antibody 16233-1-AP | Download protocol |
| Standard Protocols | |
|---|---|
| Click here to view our Standard Protocols |
发表文章
| Species | Application | Title |
|---|---|---|
Immun Inflamm Dis Vasoactive intestinal peptide exerts therapeutic action by regulating PTEN in a model of Sjögren's disease | ||
Pharm Biol Modified BuShenYiQi formula alleviates experimental allergic asthma in mice by negative regulation of type 2 innate lymphoid cells and CD4 + type 9 helper T cells and the VIP-VPAC2 signalling pathway | ||
Biomolecules Postweaning Development Influences Endogenous VPAC1 Modulation of LTP Induced by Theta-Burst Stimulation: A Link to Maturation of the Hippocampal GABAergic System | ||
J Neurosci Res Mismatch novelty exploration training shifts VPAC1 receptor-mediated modulation of hippocampal synaptic plasticity by endogenous VIP in male rats | ||
Nat Commun Sensory neurons regulate stimulus-dependent humoral immunity in mouse models of bacterial infection and asthma |